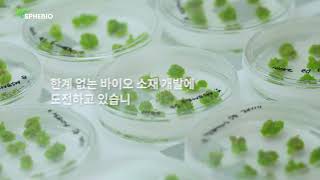

본 정보는 사람인 빅데이터를 분석한 결과이며,
실제 정보와는 차이가 발생할 수 있습니다.
-
조회수
436회
-
관심기업
7회
-
기업 키워드 검색 횟수
80회
- 자유 복장 기업 모음
- 월급을 사수하자!
- 명절선물/귀향비
- 나의 커리어 첫 시작
한눈에 보는 우리 회사, 미리 확인해 보세요!
-
영상
-
-
-
업력 6년차
2020년 8월 19일 설립
-
기업형태: 중소기업, 주식회사
기업형태
-
18 명출처: 국민연금
사원수
- 업종
- 의료용품 및 기타 의약 관련제품 제조업
- 대표자명
- 안근선
- 홈페이지
- http://sphebio.com
- 사업내용
-
생물학적 제제 제조업,화장품 및 화장용품 도매업,화장품, 비누 및 방향제 소매업,물리, 화학 및 생물학 연구개발업,기타 공학 연구개발업
- 주소
-
경북 포항시 남구 청암로 87, 541호 (지곡동,체인지업그라운드)
지도보기
3D 바이오프린팅 기반 세포응집체 (cell spheroid) 플랫폼 기술을 개발하는 목적을 가지며, 정밀한 세포응집체 제작 기술을 이용하여 균일하고 대량생산이 가능한 기술을 연구, 개발합니다.
국내 대기업 (P社 및 G社)이 선정한 바이오 스타트업이며, 정부 주도 2021년 소재부품장비(소부장) 스타트업 100에 선정되어 기술력을 인정받고 있습니다.
글로벌 바이오 기업으로 성장하기 위해 다양한 분야의 인재들을 모시고자 합니다.
저희 성장과 함께할 열정적인 인재의 많은 지원 부탁드립니다.
NICE 평가정보 출처 : 설립일, 기업형태, 업종, 대표자명, 사업내용, 주소
국민연금 출처 : 사원수
기업 직접입력 : 홈페이지, 기업소개, 기업비전
우리는 직원의 복리후생도 중요해요
-
급여제도
- 퇴직금
- 4대 보험
-
선물
- 명절선물/귀향비
-
교육/생활
- 점심식사 제공
- 음료제공(차, 커피)
-
근무 환경
- 회의실
-
조직문화
- 자유복장
인원 규모를 파악해 보세요!
- 전체인원
- 입사자
- 퇴사자


